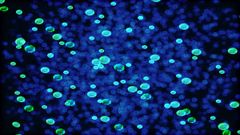
Researchers Discover New Bacteria That Can Save Mankind

Latest Research News
-

-

AI-Generated Data Build Up On The Internet May Ruin Future Iterations Of Generative Chatbots?
-

ChatGPT Wrote Medical, Engineering, Law, And Other Scientific Papers, Published In Journals
-
Researchers Discover New Bacteria That Can Save Mankind
-

Hike partners with IIIT-Delhi: Here are the details
-

New technology will predict droughts, bushfires five months in advance
-

Huawei signs research cooperation agreement Edinburgh University on artificial intelligence
-

Researchers find out ways to increase and decrease wireless signal strengths
-

Indians prefer quality net content over online freebies: Mozilla
-

Researchers at MIT working on a miniature chip to reduce size of drones
-

Researcher’s reveal new Wi-Fi system 100 times faster than current systems
-

Now smartphone can help men test sperm health at home



 Click it and Unblock the Notifications
Click it and Unblock the Notifications
-1763362932432.svg)
Stay Connected